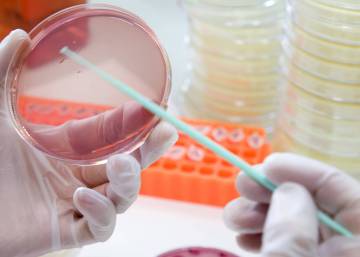

Estudo com DNA antigo identifica a salmonela como possível agente patogênico que matou entre 50% e 90% dos indígenas depois da chegada dos espanhóis
Quando Hernán Cortés pisou em solo mexicano em 1519, havia na região mesoamericana entre 15 e 30 milhões de índios. Ao final do século XVI, mal restavam dois milhões. Embora as guerras e a exploração tenham liquidado muitos indígenas, foram as epidemias que dizimaram a população. Em especial uma série de surtos de uma enfermidade desconhecida, que não tinha nome nem em espanhol nem em náhuatl, e que os mexicas chamaram de cocoliztli (o mal ou pestilência), matou entre 50% e 90% dos indígenas. Agora, um estudo com o DNA antigo pode ter identificado esse agente patogênico: a salmonela.

Margem norte da Praça Grande de Teposcolula. Sob sua base foi encontrado um cemitério com corpos de vítimas do ‘cocoliztli’ CHRISTINA WARINNER. PROJETO ARQUEOLÓGICO TEPOSCOLULA-YUCUNDAA
Nem a varíola, nem o sarampo, nem o tifo nem a caxumba causaram tantos estragos como o cocoliztli. Os escritos da época descrevem seus sintomas: febre alta, dores estomacais, diarreia, sangramento por todos os orifícios do corpo, icterícia…
A morte ocorria num prazo de três ou quatro dias, e sua taxa de mortalidade era tamanha que a única orientação aos doentes era para que se despedissem dos seus e ficassem em paz com Deus. Mas se desconhecia qual era a causa. Houve quem a visse como um castigo divino, já que afetava só os indígenas, enquanto os espanhóis pareciam imunes.
A morte ocorria num prazo de três ou quatro dias, e sua taxa de mortalidade era tamanha que a única orientação aos doentes era para que se despedissem dos seus e ficassem em paz com Deus. Mas se desconhecia qual era a causa. Houve quem a visse como um castigo divino, já que afetava só os indígenas, enquanto os espanhóis pareciam imunes.
Houve seis grandes surtos de cocoliztli no século XVI na região do antigo império mexica, sendo que as duas grandes epidemias foram as de 1545 e a de 1576. Na primeira, estima-se que 80% da população morreu. Na segunda, já com dados de dois censos de famílias espanholas e indígenas, morreram 45% dos nativos, que àquela altura eram apenas quatro milhões.
A epidemia só afetava os índios, enquanto os espanhóis pareciam imunes
Agora, um grupo de arqueólogos mexicanos e especialistas alemães em DNA antigo acreditam ter identificado no sítio arqueológico de Yucundaa-Teposcolula o agente patogênico que causou tamanha mortandade. Localizado na Mixteca Alta (Oaxaca, México), sob a praça central da cidade, esse sítio arqueológico guarda os restos de dezenas de pessoas enterradas naquela época, segundo a datação por radiação de carbono. Com as precauções exigidas pela dificuldade inerente à análise de um material genético estranho em restos com quase 500 anos de idade, os autores do estudo acharam a presença de uma bactéria, a Salmonella enterica, nos dentes de indígenas que morreram durante a epidemia.
“Devido ao contexto histórico e arqueológico, Teposcolula-Yucundaa nos oferece uma ocasião única para resolver a questão sobre o desconhecido agente microbiano responsável pela epidemia”, diz Åshild Vågene, especialista em arqueogenética do Instituto Max Planck de Ciências da História Humana e principal autora do estudo. Depois da epidemia, em 1550, os sobreviventes abandonaram o assentamento conhecido desde então como Povoado Velho de Teposcolula, descendo para um vale próximo. Isso fez com que as praças, ruas e também o cemitério parassem no tempo.
Este é o único cemitério daquele tempo sobre o qual existem referências históricas de que tenha recebido mortos pelo cocoliztli. O cemitério foi descoberto no começo deste século sob a Praça Grande. Ao todo, contaram-se 800 corpos sepultados, muitos deles em grupos, como que empilhados e enterrados às pressas. Destes, os autores da pesquisa publicada na revista Nature Ecology & Evolution analisaram a polpa dentária de peças de 24 indivíduos. Todos os dentes tinham o rastro de bactérias próprias do microbioma da boca ou da terra onde repousavam. Mas em 10 casos acharam também a marca genética da Salmonella enterica, subespécie Paratyphi C. Entretanto, não encontraram rastro do micróbio em restos humanos anteriores à epidemia.

A pesquisadora Åshild J. Vågene e seus colegas criaram um novo sistema para detectar DNA antigo de agentes patogênicos ELIZABETH NELSON
Resta esclarecer se, como aconteceu com a varíola e a gripe, a febre entérica que quase dizimou os indígenas mexicanos foi levada à América pelos conquistadores espanhóis. “Com os dados que temos atualmente não podemos saber geneticamente se o nosso S. enterica Paratyphi C veio da Europa ou se já existia no México antes da chegada dos europeus”, recorda Vågene. Mas há provas circunstanciais: Seus restos não foram encontrados nas análises de indígenas mortos antes da chegada dos espanhóis, embora até agora não tenha sido especificamente procurado. Além disso, “o que de fato sabemos é que esta bactéria já existia na Europa muito tempo antes da epidemia de cocoliztli”, acrescenta. Realmente, esse agente patogênico já foi identificado em restos humanos enterrados na Noruega 200 anos antes que Colombo fizesse suas viagens, o que sugere uma origem europeia do mal.

